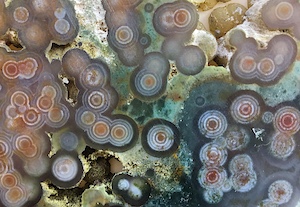
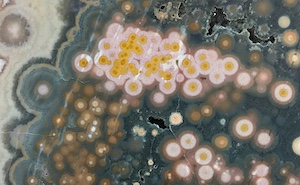

News and Announcements
Announcing the first published book on Ocean Jasper, available on Amazon.com:
"Ocean Jasper: A Natural Wonder and a Geological Mystery"
Order now in eBook format. Paperback format also now available for order, with many beautiful full color images, size is 9x6in. All proceeds from sales of this book in either format are donated to a permanent research fund dedicated to current and future research of Ocean Jasper/Spherulitic Chalcedony.